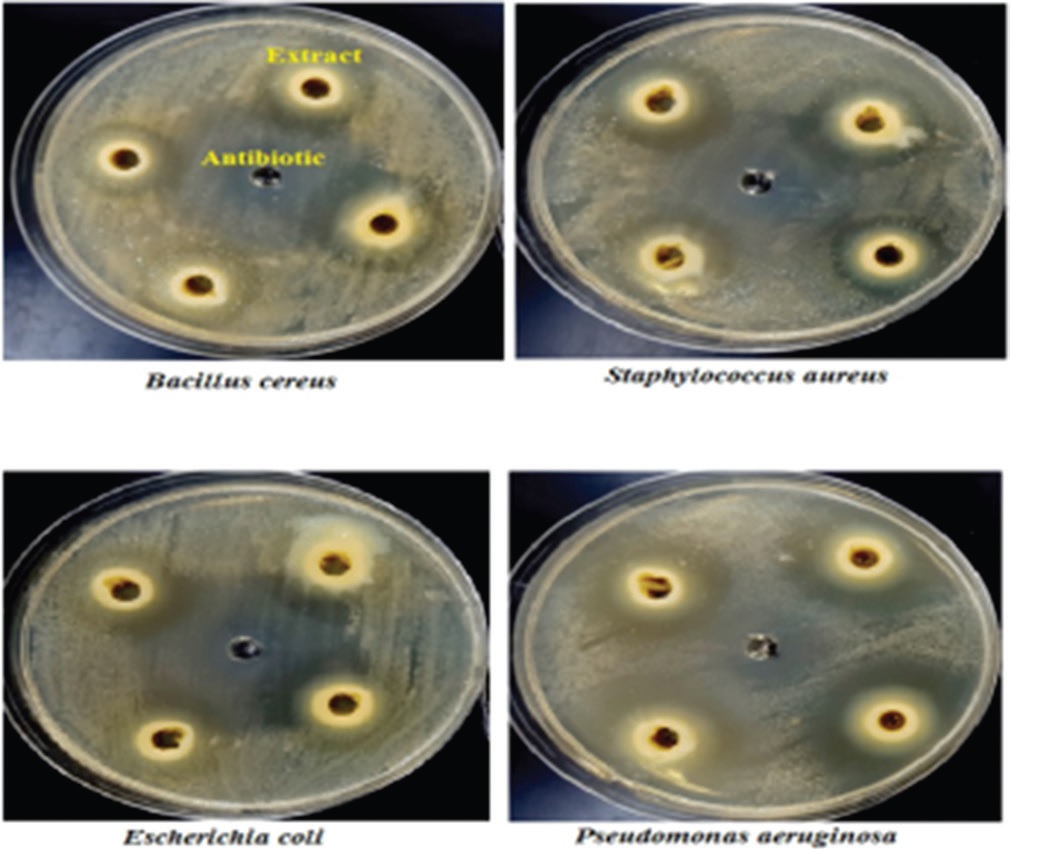
Article Image
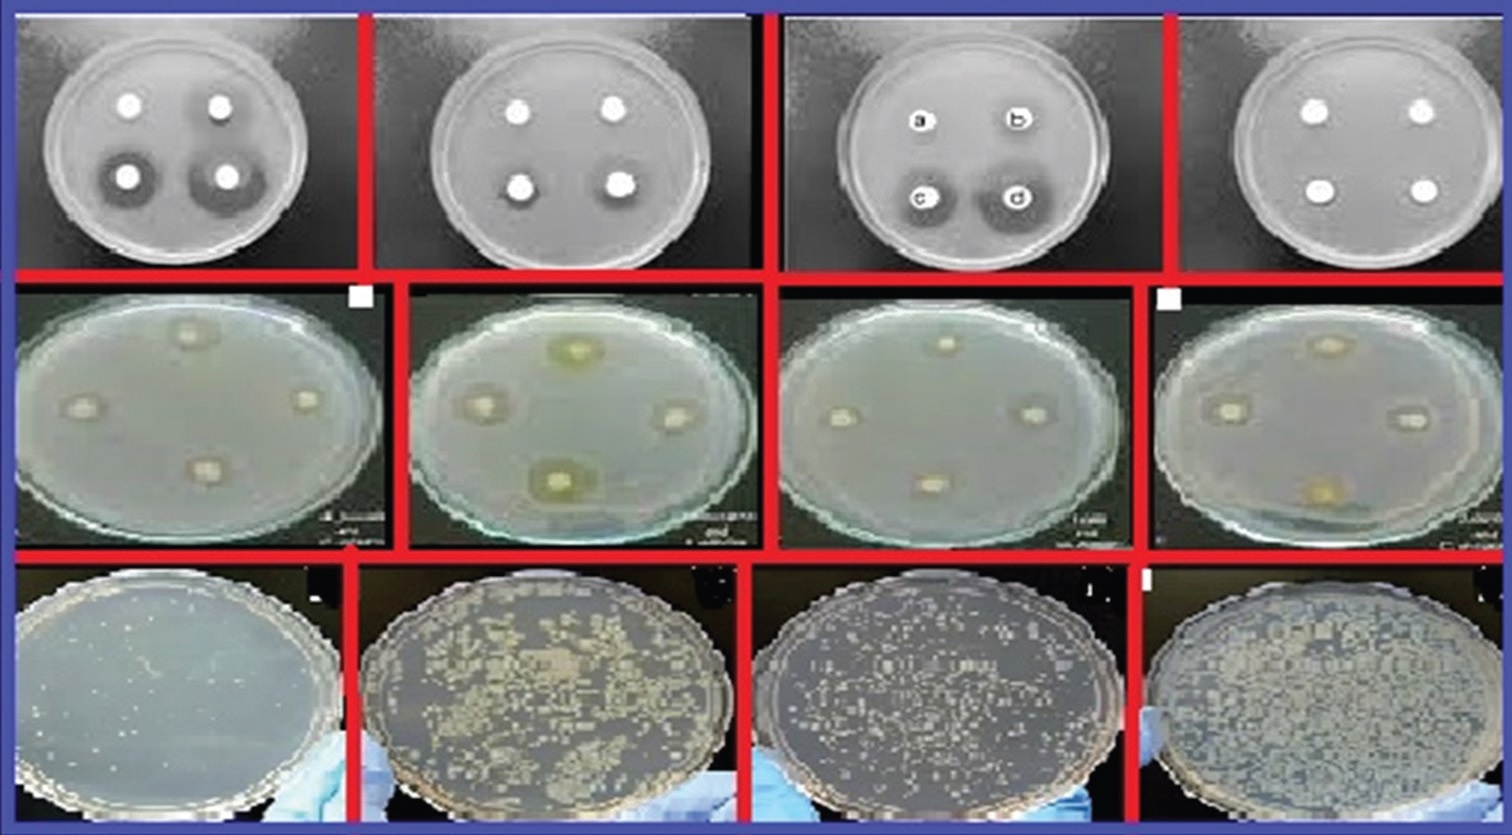
Article Image

Issue Details

February, 2019
Volume: 7, Issue: 1
📅 Published on: 05 Feb 2019
Articles in this Issue
Synthesis, Crystal Structure Refinement, and Morphological Study of Bioactive Material: Strontium and Iron-Substituted Nano-Hydroxyapatite: Ca10-xMx(PO4)6(OH)2 (M=Sr and Fe and 0 ≤ x ≤ 0.1)
Authors: O. P. Shrivastava*, Ramesh C. Deka, Rashmi Chourasia, Rasnadevi
DOI: 10.22607/IJACS.2019.701001 | Pages: 1-11

Synthesis, Crystal Structure, and Characterization of Manganese Metal-organic Framework with Improved Electro Catalytic Activity for Supercapacitor Application
Authors: G. Krishnamurthy*, B. M. Omkaramurthy
DOI: 10.22607/IJACS.2019.701002 | Pages: 12-19

Synthesis of Biologically Active Silver Nanoparticles Using Tinospora Cordifolia Leaf Extract For Antimicrobial Applications
Authors: P. Deepika, H. M. Vinusha, Muneera Begum*, H. J. Bharath Kumar, N. D. Rekha
DOI: 10.22607/IJACS.2019.701006 | Pages: 35-38